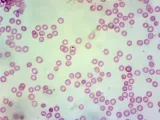
kamera-mikroskopowa-dlt-cam-basic-2-mp-usb-2-0-waga-z-opakowaniem-0-19-kg-model-dlt-cam-basic-2-mp-usb-2-0

Kamera mikroskopowa DLT-Cam Basic 2 MP USB 2.0
339,00 zł
342,39 zł
z 98 sztuk
z 98 sztuk
Darmowa dostawa
14 dni na odstąpienie od umowy
DeltaOptical
Sprawdzony sklep | Kupujesz od firmy
100%
kupujących poleca ten sklepw ciągu ostatnich 12 miesięcy
O sprzedającym
Szczegółowe dane, kontakt, informacje



 -gazetkę
-gazetkę














